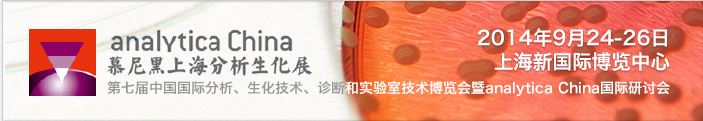
大象视颇dxvv55xyz

企业新闻
参展第七届慕尼黑上海分析生化展
时间:2014-09-27 来源:EASTWIN浏览次数:68
第七届慕尼黑上海分析生化展(analytica China)两年一次的仪器界盛会圆满结束,这次国际性的平台更是我们国产仪器的展示机会!
人潮涌动,不再单单流连在国外展台,国产仪器的高性价比、日益增进的生产工艺吸引着来自全球的参会者,更创造了国产仪器在国内发展、走出国门的诸多商机!
北京东胜创新生物科技有限公司的子工厂—苏州东胜兴业,作为总部的代表参加了这一盛会,携手入围《国产好仪器手册》的东胜龙ETC811 PCR仪亮相会议,以其性能佳、价格优的特点深受客户好评。
该产品目前推出了极大的让利促销—裸奔价,24811元即可送货上门
赢在细节:
开机自动体检仪器 压盖自动适配管型
运行自动冷藏样本 完成自动报告情况



本文标签:

 English
English 简体中文
简体中文





